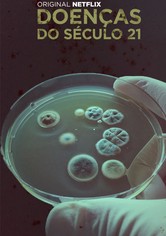
Doenças do Século XXI

Assistir Go! Go! Loser Ranger! online: streaming, compre ou alugue
Você pode assistir "Go! Go! Loser Ranger!" no Disney Plus em Stream legalmente.
Não há opções gratuitas para assistir Go! Go! Loser Ranger! no momento. Se quiser saber quando estiver disponível gratuitamente, clique em 'Grátis' nos filtros acima e ative o sino de notificações.